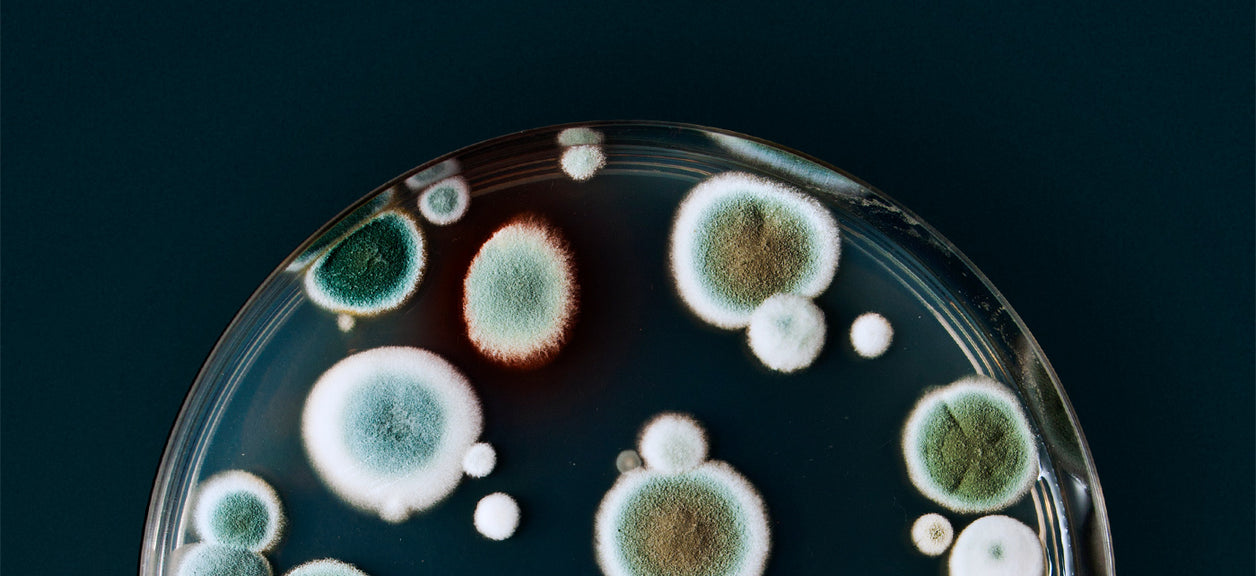

Sneaky Summer Spores: Unmasking Summer Mold
Each month, we’re going to shed light on a seasonal allergen that seems to squirm into our lives (and lungs) to disrupt our everyday routines. Learn what it is, why it’s here, and how to avoid it so you can enjoy the more important things.
While many associate allergies with spring pollen or fall ragweed, summer brings its own unique allergen: mold. Often overlooked, mold can be a significant trigger for allergy sufferers during the warmer months.
By the time August hits, it’s easy to shift into peak summer-mode. That means time spent thinking about beaches, barbeques, and book-reading. The last thing on your mind is the allergens popping up in your surroundings. However, late summer provides the perfect storm of factors to incubate mold in and around your home.
Caught us off season? Check out our blogs on spring allergies and fall allergies here!
Understanding Mold Allergies
What is Mold?
Mold is a type of fungus that thrives in warm, damp environments. It reproduces by releasing tiny spores into the air, which can trigger allergic reactions when inhaled.
Symptoms of Mold Allergies
Common symptoms include:
- Sneezing
- Runny or stuffy nose
- Coughing and postnasal drip
- Itchy eyes, nose, and throat
- Watery eyes
- In severe cases, difficulty breathing
Fast facts
• Where it hides: Places that are warm and wet.
• What to look for: A musty smell—that could be the first sign of mold in hard-to-see places.
• Notable numbers: 77 degrees Fahrenheit. This is the temperature where mold begins to thrive.
The conditions that make it prevalent
Mold thrives in environments that are warm and wet. Because summer temperatures hit high numbers, many places in your home can easily hit that 77 degrees Fahrenheit mark. That temperature, paired with leaky pipes, a humid bathroom, or anything else wet, is a recipe for summer mold. Once mold spores interact with heat, humidity, and a food source (such as dust or dirt), they begin to multiply.
Why Summer Mold is Particularly Problematic
When mold moves in, it has an array of effects on both your body and abode. Left untreated, it can cause damage to your home that is expensive to repair. Because mold can hide in and between the walls of your house, it’s easy to overlook the damage. The effects on your body can cause symptoms such as coughing, wheezing, and even skin irritation. If you have a mold allergy or chronic lung disease, these symptoms will likely be worse.
Five Tips to Prevent Summer Mold
Luckily, it’s easy to prevent mold with a little bit of foresight and common sense.
• Use an air conditioner to keep temperatures below the level mold needs to grow rapidly.
• Ventilate your bathroom when showering to prevent moisture from building up.
• Check windows and doors after it rains for any water accumulation.
• Keep surfaces free of dust and dirt to limit mold’s food source.
• Use a HEPA air purifier, like Airmega, to filter out mold fragments and spores in the air.
Disclaimers
1Coway air purifiers have been proven to trap dust, pollen, dander, viruses and bacteria in the air based on KCL (Korea Conformity Laboratories) testing.They have been tested in a 30㎥ size chamber according to the Korea Air Cleaning Association standard (SPS-KACA 002-132:2022 Modified) to measure the 0.01㎛ size of particle removal rate. It was tested on maximum airflow speed in normal room temperature and humidity conditions. The performance may vary in the actual living environment of customers.
→ Tested with Airmega Aim, 50, 100, 150, 160, Tower AP-1216L, Mighty AP-1512HH, MightyS AP-1512HHS, 200M, Icon, IconS, 230, 240, 250, 250 Art, 250S, 300, 300S, 350, 400, 400S, 450, ProX
299.97% of viruses, bacteria, fungi and pollen were verified to be removed from the air for Coway air purifiers which have Green True HEPA™ filter applied based on the Japan Food Research Laboratories(JFRL) testing according to JEM 1467 standard.
→ Tested with Coway Airmega Mighty AP-1512HH, MightyS AP-1512HHS, 250, 250 Art, 250S, 300, 300S, 400, 400S
→ All tested by JFRL and received above result within below time.
4The concentration of ammonia, acetaldehyde and acetic acid were proven to be removed within 30 minutes by FCG Research Institute, Inc. Human Life Science Lab. It is not a demonstration result in the actual use space. Not all odors and gases may be supported. → Tested with Coway Airmega 150, 160, Mighty AP-1512HH, MightyS AP-1512HHS, 400, 400S
5The coverage area of the air purifier is based on an area where the air cleaner can make two air changes per hour (ACPH). An air change per hour translates to how many times an air purifier can clean an area, assuming the height of a ceiling to be 8 ft, in one hour. Therefore ** means two air changes per hour means that the cleaner can clean the area once every 30 minutes and * means air changes per hour means that the air purifier can clean the area once every 60 minutes.
10Terms and conditions apply. Discounts, including promotions, coupons, bundle discount and subscription discount, cannot be stacked on top of other coupons. During promotional periods, discount codes will not be able to be applied to orders. Promo codes may apply to products only—filters, accessories, and new products within 3 months of the release date are not included.